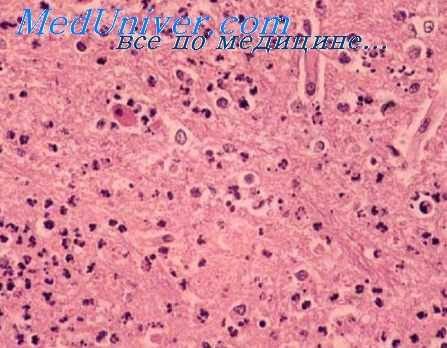
энцефаломиелит лошадей
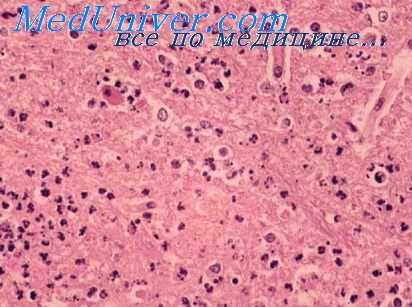
энцефаломиелит лошадей

Восточный энцефаломиелит лошадей. Эпидемиология восточного энцефаломиелита
Добавил пользователь Alex Обновлено: 28.11.2025
[Eguine West encephalomielitis (EEE) (англ.); Seuchenhafte Hinruckenmarkentzundung der Pferde, Amerikanische Hinruckenmarkentzundung (нем.)]
Восточный американский энцефаломиелит лошадей (ВАЭЛ) — болезнь однокопытных животных, характеризующаяся поражением преимущественно ЦНС, жел-тушностью слизистых оболочек и атонией ЖКТ. Вирус выделили в 1933 г. Тен Брук и Меррилом. Позже его выделяли от больных людей, а также от птиц и комаров некоторых видов. Болезнь распространена в центральных районах США, в Бразилии, Канаде, странах бассейна Карибского моря и восточных районах Южной Америки. Вирус выделен на Филиппинах. В штате Джорджия (США) ВАЭЛ регистрируют в виде эпизоотии. В США ВНА к вирусу обнаружены у 18—26 % Диких и домашних свиней. Однако клинических признаков инфекции у них не наблюдалось. В 1971 г. от Culiseta morsitans в окрестностях Нью-Йорка выделен вирус ВАЭЛ. В связи с этим, в 1977—1979 гг. изучали биологию этого вида насекомых и оценивали векторный потенциал в трех областях эндемического очага — в 40 км от Сиракуз (Нью-Йорк), в центре и периметре болот и возле селений. Показано, что Culistera. morsitans размножается 1 раз в год, продолжительность жизни его 8—12 недель, он строго орнитофилен. Популяции насекомых различаются в размерах и наблюдаются от середины мая до начала сентября. Потенциальный вектор Culistera. morsitans, такой же как у Culistera melanura. Насекомые локализуются в очагах ВАЭЛ в период распространения вируса.
Клинические признаки и патологоанатомические изменения. У инфицированных лошадей наблюдается лихорадка и виремия, затем появляются симптомы поражения ЦНС: возбуждение, изменение поведения, сонливость и паралич. Погибает до 20 % заболевших. При патологоанатомическом исследовании отмечают деструкцию серого вещества головного мозга.
Морфология и химический состав. Размеры вирионов варьируют от 20 до 58 нм, частицы сферической формы.
Вирус инактивируется в течение 10 мин при 60 °С, а также при замораживании и оттаивании и обработке СОг, эфиром и дезоксихолатом, сохраняется при -20 и -70 °С. Воздействием азотистой кислотой на инфекционную РНК. удавалось получать мелко-бляшечные мутанты, которые отличались от исходного вируса. Воздействие гидроксиламина в условиях рН 6,1 ведет к более быстрой, чем при рН 9,1, инактивации вируса. Вирус ВАЭЛ удается концентрировать центрифугированием в градиенте плотности сахарозы (45 %) В течение 2,5 ч при 27 000 мин-', а затем в 30—50 %-ном растворе сахарозы за 20 ч при 24 000 мин-1. Данный метод позволяет сохранять 90 % Инфекционное™ вируса.
Антигенная структура. Известно, что белок оболочки вируса ВАЭЛ угнетает иммунный ответ здоровых мышей (СВАхС57В1) F на гетеро АГ при внутривенном введении за 24 ч до иммунизации эритроцитами барана (I). Определена топология АГ детерминант, ответственных за проявление ГА активности в генах вируса ВАЭЛ. С помощью панели с 17 образцами монАТ анти-ГА идентифицирован высококонсервативный С домен, распознаваемый группоспецифическими монАТ, в гене белка Е2 обоих вирусов. Эти монАТ ингибировали агглютинацию следующих альфавирусов: ЗАЭЛ, лесов Семлики, Чикунгунья, Аура, Гета, Синдбис и Пиксина. Определено, что доминанта С-региона ассоциирована с аминокислотными остатками порядковых номеров 59 и 232, что было продемонстрировано при определении нуклеотидной последовательности гена белка Е2 трех выделенных вариантов венесуэльского энцефаломиелита лошадей (ВЭЛ).
Антигенная активность, антигенная вариабельность и родство. В сыворотке крови переболевших лошадей и людей имеются AT, участвующие в РСК, РН и РЗГА, сравнительная динамика которых не изучена. В антигенном отношении вирус ВАЭЛ выше, чем вирус ЗАЭЛ. В течение 1971 г. наблюдали вспышку энцефалита лошадей в США, при которой из 1982 проб (кровь, мозг, селезенка и др. ткани) от 1551 лошади выделено 76 изолятов вируса ВАЭЛ. Большинство (51,6—76,1 %) Инфицированных лошадей были из юго-восточных штатов. Изоляты идентифицировали в РН и РСК. 58 из 76 изолятов выделены из мозга и селезенки, 18 из сыворотки или крови. У 40 не вакцинированных лошадей был изолирован вирус ВАЭЛ и 26 из них (65 %) имели моноспецифические AT к вирусу ВАЭЛ, 4 имели более высокий титр к вирусу ВАЭЛ, чем к вирусу ЗАЭЛ; 5 имели ВНА к обоим вирусам. Одна сыворотка имела моноспецифические AT к вирусу ЗАЭЛ в РН и 4 сыворотки не имели AT Из 67 инфицированных вирусом ВАЭЛ лошадей 54 (80,6 %) погибли и 4 (6 %) выжили после болезни. Во время эпизоотии 1971 г. 30 % изолятов (76/67) отнесены к вирусу ВАЭЛ, 34 % (87/80) к ЗАЭЛ (эпизоотический штамм) и 36 % (93/80) к вакцинному штамму вируса ЗАЭЛ. Из 652 обследованных сывороток 119 (18,3 %) имели ВНА к вирусу ВАЭЛ (5).
Штаммы вируса ВАЭЛ, выделенные в отдаленных геофизических районах, в АГ отношении различны. Так, восемь штаммов этого вируса, полученных в США, на Ямайке, в Доминиканской Республике, отнесены к североамериканскому подтипу; другие восемь, выделенные в Панаме, Гвинее, Бразилии, Аргентине и на о. Тринидад, — к центрально-южно-американскому подтипу.
Выявлено четыре серотипа вируса ВАЭЛ. 1-й тип включает пять подтипов: 1 А, 1 В, 1С, ID и IE. В АГ-отношении вирус ВАЭЛ отличается от вирусов WEE и VEE в РСК, РН на мышах и в культуре клеток. Однако в РЗГА установлено родство его с другими альфавирусами. При пассировании и последующем клонировании вируса в культуре клеток КЭ можно получить АГ различные варианты вируса ВАЭЛ (шт. Агу-В). В этой же системе удалось получить два варианта (М и D) вируса, различных по патогенности для мышей и по антигенности в РН на мышах. По иммуногенным свойствам вирус ВАЭЛ больше близок к вирусу ВЭЛ, чем к другим альфавирусам.
Для реакции более пригодны эритроциты только что вылупившихся цыплят и утят. Эмбриональный вирус, обработанный сахарозой и ацетоном, повышает ГА активность. Вирус содержит гемолизин, а также интерферирует со многими вирусами, включая альфа-, флави-, миксо - и пикорнавирусы. Используется в качестве индикатора на присутствие интерферона.
У больных лошадей вирус выделяется с секретом носовой полости, мочой, молоком. У лошадей виремия невысокая, и они, вероятно, являются, так же, как и люди, тупиком инфекции.
Экспериментальная инфекция. Легко воспроизводится на белых мышах, крысах, морских свинках, кроликах, обезьянах, белках, хлопковых крысах, оленях, козах, овцах, коровах, голубях и цыплятах при интрацеребральной инокуляции вируса. Наиболее чувствительны мышата и 4-5-недельные сирийские хомячки. Белые крысы, морские свинки и кролики невосприимчивы к вирусу при периферическом заражении. У мышей болезнь протекает как энцефалит. Инкубационный период 2—3 дня, поражается ЦНС. Для мышей вирус ВАЭЛ более вирулентен, чем вирусы ЗАЭЛ и ВЭЛ. Вирус высоко патогенен для КЭ. У фазанов и мелких птиц из отряда воробьиных развивается летальное заболевание. Свежевылупившиеся цыплята (до 12-часового возраста) пригодны для пассирования вируса в лабораторных условиях.
Для изучения выживаемости самок комаров Ае. albopictus, An. quadrimaculatus и С. pertuTbans кормили на цыплятах, зараженных вирусом восточного лошадиного энцефаломиелита (ВВЛЭ), и в разные сроки после заражения определяли выживаемость комаров. Контролем служили самки, которых кормили на цыплятах, не зараженных ВВЛЭ. В других опытах самок An. quadrimaculatus и С. perturbans заражали ВВЛЭ внутриторакально. Установлено, что при заражении Ае. albopictus. An. quadrimaculatus (перорально и интраторакально) и интраторакальном заражении С. perturbans ВВЛЭ не оказывал никакого влияния на выживаемость самок. Однако при пероральном заражении самок С. perturbans выживаемость их сильно сокращалась.
Культивирование. Вирус ВАЭЛ размножается в КЭ, в культуре клеток ФЭК, эмбриона мыши, хомяка, обезьяны, морской свинки, а также в клетках Hela, индуцируя цитопатические изменения. Из первично трипсинизированных тканей наиболее пригодна почка хомяка 20—25-дневного возраста. Культуру клеток выращивают на среде Игла с добавлением 2 % сыворотки хомяка. ЦПД вируса проявляется через 24 ч. В культуре ФЭК он образует бляшки. В некоторых линиях человеческих и куриных клеток при 31 °С может развиваться хроническая инфекция. Вирус ВАЭЛ размножается в организме экспериментально зараженных комаров и клещей. Имеются сведения о культивировании вируса в эмбрионах рыб и тканевой культуре измельченных личинок комара Aedes egypti.
Реализация генетической информации тогавирусов происходит в цитоплазме клетки в тесной ассоциации с клеточными мембранами. После инфекции и депротеинизации родительская РНК прикрепляется к мембране, с мембранами ассоциированы также вирусная РНК-полимераза и вирусспецифические полирибосомы. Репликация РНК тогавирусов идет по обычному для РНК-содержащих вирусов типу и проходит стадию репликативной промежуточной формы. Вирионная РНК, распадаясь после депротеинизации вириона на более мелкие фрагменты, обеспечивает трансляцию вирусспецифических белков. Предполагается, что эти же фрагменты РНК служат и матрицей для репликации. Репликация вирионной 42—49S РНК происходит в особом репликативном комплексе, хотя неясно, что является матрицей для репликации такой РНК. Синтез более мелких молекул РНК (15—26—33S), обладающих матричной активностью, происходит, видимо, в другом репликативном комплексе. Полипептиды вириона (или часть) образуются расщеплением более крупных белков предшественников. Ассоциация РНК с белком нуклеокапсида и образование нукле-окапсида происходят на внутрицитоплазматических мембранах.
Сформировавшиеся нуклеокапсиды мигрируют к модифицированным участкам наружной мембраны клетки, в которой клеточные белки заменены вирусспецифиче-скими гликопротеинами. Ассоциация нуклеокапсида с модифицированной мембраной и «одевание» нуклеокапсида происходят в процессе выхода вириона из клетки путем отпочковывания. По-видимому, некоторые структурные полипептиды модифицируются (расщепляются, дегликозилируются) уже на стадии вириона.
Источники и пути передачи инфекции. Источником инфекции служат больные животные. Инфекция передается комарами. В распространении вируса могут участвовать более 20 видов комаров Culicinae, однако основной переносчик пока не установлен. В распространении вируса в естественных условиях, по-видимому, участвуют дикие птицы. Переносчиком вируса среди птиц является Culiseta melanura. Птицам (скворцам и белогорлым воробьям) вирус, очевидно, передается Cuiiseta morsitons. Переносчик вируса лошадям и людям неизвестен. Среди фазанов болезнь может распространяться при отсутствии членистоногого переносчика. Среди лошадей возможно контактное заражение. Распространению инфекции среди мышей может способствовать каннибализм. Исследовали наличие вирусов ВАЭЛ и HJ в сперме индюков, зараженных данными вирусами, и возможность их передачи при искусственном осеменении. Через 1—2 дня после заражения индюков внутримышечно дозой 2000 БОЕ/0,1 мл того или иного вируса наблюдали слабую депрессию, потерю аппетита, виремию. Через 1—5 дней вирусы обнаруживали в сперме и, по мнению авторов, она является одним из векторов передачи вирусов.
В естественных условиях вирус ВАЭЛ вызывает эпизоотии среди лошадей, фазанов и эпидемии среди людей. Клинически у человека болезнь протекает в виде энцефалита с большим процентом летальности или тяжелых последствий в виде умственной слабости. Возможна инаппарантная инфекция. В природе вирус выделяют из комаров Mousonta, Anopheles, Culiseta разных видов Culicoides. Он обнаружен в организме птичьих клещей Dermanyssus gallinae и блох Eomenacanthus stramineus и Menopon pallidum. В США наиболее часто его выделяли из комаров Culiseta melanura.
Восточный энцефаломиелит лошадей. Эпидемиология восточного энцефаломиелита
Клиника и диагностика энцефаломиелита лошадей. Лечение и профилактика энцефаломиелита лошадей
Развитие инфекционного процесса при энцефаломиелите лошадей сходно с патогенезом восточного энцефаломиелита лошадей (ВЭЛ), но степень морфологических и функциональных поражений значительно меньше Патологические изменения в виде очаговых некрозов и воспалительных лимфомоноцитарных инфильтратов и глиальной инфильтрации выявляются преимущественно в сером веществе головного и спинного мозга, в таламусе, базальных ганглиях, globus pallidum и в стволе мозга При неблагоприятном течении болезни выявляют кровоизлияния в области ствола мозга
У реконвалесцентов вырабатывается стойкий иммунитет
Инкубационный период составляет 5-10 (от 4 до 21) дней
В большинстве случаев болезнь протекает в виде остролихорадочного заболевания с быстрым подъемом температуры до 40 °С, возникновением головной боли, тошноты и рвоты, развитием прострации и менингеального синдрома У детей, особенно в возрасте до 1 года, отмечаются судороги, ригидность мышц затылка и спины, выбухание большого родничка, угнетение сознания, заторможенность, сонливость, может развиться кома
В гемограмме определяют умеренно выраженный нейтрофильный лейкоцитоз, в цереброспинальной жидкости выявляют невысокий лимфоцитарныи плеоцитоз до 50-100 клеток в 1 мкл и увеличение содержания белка (гиперпротеинорахия) При КТ и МРТ головного мозга выявляют очаги поражения в базальных ганглиях, таламусе и стволовых отделах
Спустя 1-1,5 нед проявления болезни подвергаются обратному развитию, однако более чем у половины детей младшего возраста в течение 1-2 лет могут сохраняться судороги, тремор, нарушение умственного развития и психические расстройства, а у взрослых может развиться паркинсонизм
Летальность, в среднем, составляет 3%, у детей раннего возраста могут длительно сохраняться остаточные неврологические расстройства
Западный энцефаломиелит лошадей можно предполагать в случаях возникновения остролихорадочного заболевания с симптомами менингоэнцефаломиелита у детей, реже у взрослых из эндемических очагов болезни в летне-осенний сезон на фоне эпизоотии среди лошадей Дифференциальный диагноз проводят с другими вирусными нейроинфекциями
Верификация диагноза энцефаломиелита лошадей достигается выделеним WEEV из крови и цереброспинальной жидкости больных в лихорадочный период, реже из ткани мозга погибших, с использованием клеточных культур или лабораторных животных Разработаны методы PCR-диагностики
Серологическая диагностика основана на изучении РТГА и РН с парными сыворотками крови Ранним методом серодиагностики может служить обнаружение специфических антител класса IgM к WEEVb ИФА, однако следует учитывать возможность перекрестных реакций с другими вирусами комплекса WEE
Больным проводят патогенетическое лечение, специфическая терапия не разработана
Специфическая профилактика достигается применением инактивированной вакцина людям из групп высокого риска заражения. Большое значение имеют мероприятия по борьбе с комарами и защита от их нападения.
Информация на сайте подлежит консультации лечащим врачом и не заменяет очной консультации с ним.
См. подробнее в пользовательском соглашении.
Восточный энцефаломиелит лошадей (ВЭЛ) — природно-очаговый трансмиссивный вироз, распространяемый гомарами в американском регионе, характеризующийся диффузным воспалением головного и спинного мозга, протекающий с высокой лихорадкой и выраженными много очаговыми неврологическими симптомами.
Возбудитель болезни был выделен в 1933 г. С.Ten Broeck и L.T. Gnthner из мозга лошади при изучении эпизоотии энцефаломиелита среди лошадей в восточных районах США (New Jersey). Роль вируса в патологии человека была установлена в 1939 г. L.D. Fothergill и L.T. Webster.
Возбудитель — Eastern equine encephalitis virus (EEEV), относится к poду Alfavirus семейству Togaviridae и образует антигенный комплекс вирусов ЕЕЕ. Различают 2 североамериканских и 1 южноамериканский подтипы вируса.
Сферические вирусные частицы диаметром 50-70 нм состоят из наружной гликопротеиновой оболочки, липидн ого слоя и нуклеокапсида, заключающего односпиральную инфекционную РНК из 12 000 нуклеотидов. Геном вируса кодирует синтез 4 неструктурных белков (NS 1-4), выполняющих функцию вирусной репликазы и транскриптазы, и 3 структурных протеинов: С — капсидного белка, Е1 и Е2 оболочечных гликопротеинов, которые обеспечивают взаимодействие вируса с рецепторами клетки-мишени (Е2) и эндоцитоз вирионов (Е1) и индуцируют в организме хозяина синтез нейтрализующих (Е2) и гемагглютинирующих (Е1) антител
Вирус реплицируется в клетках-мишенях с развитием цитопатического эффекта, является патогенным для клеточных линий (фибробласты куриных эмбрионов, Hela и др.), вызывает гибель куриных эмбрионов и летальное заболевание у новорожденных белых мышей, морских свинок, хомячков и других лабораторных животных. EEEV инактивируется формалином, пропиолактоном, УФ-излучением, но хорошо переносит высушивание и низкие температуры.
Восточный энцефаломиелит лошадей — природно-очаговая трансмиссивная инфекция. Основным резервуаром вирусов в природе являются различные виды лесных птиц; среди фазанов, перепелов, страусов и эму наблюдаются эпизоотии болезни. Дополнительным резервуаром вируса служат лошади, среди которых возникают эпизоотии с высокой летальностью. Человек является тупиковым хозяином EEEV. Механизмы сохранения вируса в зимний период не выяснены.
Механизм заражения — кровяной трансмиссивный, реализуемый при кровососании инфицированных комаров. Основным переносчиком вирусов являются орнитофильные комары Cuhseta melanura. Для заражения людей наибольшее значение имеют комары Aedes spp. (Аё. sollicitans), Culex spp. (Cx. nigripalpus), Coquillettidia spp. (C. perturbans) и др., питающиеся кровью животных и человека.
Заболевания людей возникают в конце летнего и начале осеннего сезонов, особенно в периоды жаркого и влажного лета, и обычно следуют за эпизоотиями среди лошадей. Контингентами высокого риска заражения являются сельские жители, фермеры, работающие в лесу люди; мужчины заражаются чаще женщин. Описаны случаи внутрилабораторного заражения.
Природные очаги восточного энцефаломиелита лошадей расположены в восточных штатах США (побережье Атлантического океана и Мексиканского залива), в Канаде (Онтарио), в Центральной Америке (Панама, Сальвадор), в Карибском регионе (Доминиканская Республика, Куба, Тринидад, Ямайка) и в Южной Америке (Аргентина, Бразилия, Гайана, Колумбия), где ежегодно регистрируется от нескольких до десятков случаев болезни. Несмотря на низкую заболеваемость, ВЭЛ является важной проблемой в связи с большой частотой летальных исходов болезни (от 30% до 75%).
Клиника и диагностика восточного энцефаломиелита. Лечение восточного энцефаломиелита
После трансмиссивной инокуляции и первичной вненейронной репликации вирус поступает в кровь, обусловливая кратковременную виремию, затем гематогенно достигает ткани головного и спинного мозга. Репликация вируса в нервных клетках сопровождается развитием цитопатического эффекта и некрозом нейронов, олигодендроглии, индуцирует распространенную периваскулярную лимфомононуклеарную инфильтрацию в виде «муфт» вокруг артериол и венул. Наиболее глубокие повреждения выявляются в области белого вещества головного и спинного мозга, в корковых отделах, в таламусе и базальных ганглиях. Закономерно отмечаются отек и воспалительная инфильтрация мозговых оболочек. В клетках олигодендроглии могут обнаруживаться вирионы EEEV.
Формирование иммунного ответа, в частности выработка нейтрализующих антител к Е2 гликопротеинам EEEV, препятствующих прикреплению вирионов к клеткам, способствует элиминации вирусов и выздоровлению. Персисгарование EEEVb нервных клетках не установлено. У реконвалесцентов вырабатывается стойкий иммунитет, повторные заболевания у них не описаны.
Восточный энцефаломиелит лошадей отличается тяжелым течением. Частота бессимптомных форм инфекции колеблется от 50-23 (у взрослых) до 8 (у детей моложе 4 лет) на 1 манифестный случай болезни.
Инкубационный период составляет от 4 до 10-15 дней.
Заболевание развивается остро с повышением температуры до 39-40 °С, появлением быстро нарастающей по интенсивности головной боли, головокружения, тошноты и рвоты. Быстро развивается прострация и дезориентация, у многих больных появляются судороги, тремор, спастические параличи, возникают пастозность лица и конечностей, цианоз кожи. В течение нескольких дней развивается ступор, а затем и кома с гибелью более 1/3 больных.
Радиографические методы исследования (КТ и МРТ) выявляют значительные очаги поражения в области базальных ганглиев, таламуса и ствола мозга.

В гемограмме в лихорадочный период выявляется нейтрофильный лейкоцитоз. В цереброспинальной жидкости определяется лимфоцитарный плеоцитоз до 600-2000 клеток в 1 мкл и умеренная гиперпротеинорахия.
Прогноз серьезный, летальность колеблется от 36% (в США) до 75%. У реконвалесцентов, чаще у детей, в течение длительного времени наблюдаются остаточные явления в виде нарушений психического развития и поведения, умственной отсталости, стойких параличей, судорожных состояний, которые могут потребовать длительного содержания пациентов в условиях ОРИТ.
Восточный энцефаломиелит лошадей можно предполагать в случаях развития у людей из энзоотических очагов остролихорадочного заболевания с быстрым прогрессированием признаков энцефаломиелита, возникающего в летне-осенний период на фоне эпизоотии среди лошадей. Дифференциальный диагноз проводят с другими вирусными нейроинфекциями.
Верификация диагноза восточного энцефалита лошадей достигается изоляцией EEEV из крови больных в лихорадочную фазу, из цереброспинальной жидкости, а при летальном исходе из мозговой ткани с использованием клеточных линий (фибробласты куриного эмбриона и др.) или лабораторных животных (новорожденные белые мыши и др.), которые погибают от неврологических поражений. Разработаны методы RT-PCR диагностики.
Основным способом специфической диагностики восточного энцефаломиелита остаются серологические методы: определение противовирусных антител класса IgM в ИФА в ранние сроки болезни, динамическое определение антител с помощью РТГА (1-2-я недели болезни), РСК (2-3-я недели) и РН (3-4-я недели). В связи с тем, что ЕЕЕV является единственным представителем антигенного комплекса ЕЕЕ, перекрестные серологические реакции исключаются.
Специфическая терапия не разработана. В эксперименте отмечен положительный эффект от применения рибавирина. Больным проводят патогенетическую терапию, профилактику и лечение осложнений.
В ветеринарии используют инактивированную вакцину для птиц и лошадей. Людям из групп высокого риска заражения и лабораторным работникам по эпидемиологическим показаниям проводят вакцинацию инактивированной формалином вакциной, при этом следует учитывать, что вакцина из северных штаммов вируса не эффективна в отношении южных штаммов. Большое значение в предупреждении болезни имеют борьба с гомарами и индивидуальные средства защиты от их нападения.
ЭНЦЕФАЛОМИЕЛИТЫ ЛОШАДИНЫЕ
ЭНЦЕФАЛОМИЕЛИТЫ ЛОШАДИНЫЕ (греческий enkephalos головной мозг + миелит[ы]) — инфекционные болезни, характеризующиеся поражением головного и спинного мозга, а также мозговых оболочек.
Энцефаломиелиты лошадиные встречаются в странах Америки и их обычно рассматривают как группу американских лошадиных энцефаломиелитов. Различают восточный, западный и венесуэльский лошадиные энцефаломиелиты, что связано с местами возникновения и изучения первых эпизоотий этих болезней (восточные и западные штаты США, Венесуэла).
Восточный лошадиный энцефаломиелит
Вирусная природа болезни у лошадей установлена Тенбреком и Гилтнером (С. Ten Broeck, L. Т. Giltner) с сотрудниками в 1933 году во время эпизоотии энцефаломиелита среди лошадей в восточных штатах США. Фотергиллом и Уэбстером (L. D. Fothergill, L. Т. Webster) с сотрудниками в 1938 года была доказана этиологическая роль вируса восточного энцефаломиелита лошадиного в случаях энцефаломиелита человека.
Заболевания восточным энцефаломиелитом лошадиным у людей в виде спорадических случаев или небольших вспышек регистрируются в восточных и северных штатах США, прилежащих к ним районах Канады, в ряде стран Центральной и Южной Америки (Мексика, Куба, Доминиканская Республика, Ямайка), на острове Тринидад. Такие вспышки болезни у людей нередко возникают на фоне эпизоотии среди лошадей.
Возбудитель восточного энцефаломиелита лошадиного — вирус, относящийся к группе арбовирусов (см.), переносится членистоногими. Он принадлежит к роду Alphavirus сем. Togavirida (см. Альфа-вирусы). Вирионы вируса имеют сферическую форму, диаметр их около 60 нм; содержат инфекционную РНК. Вирус инактивируется под действием формалина, бетапропиолактона, УФ- облучения; длительно сохраняет инфекционную активность при низких температурах и в высушенном виде. Он хорошо размножается во многих клеточных культурах (фибробласты куриного эмбриона, клетки HeLa, мышиные фибробласты линии L, клетки почек обезьян макак-резусов и человека) и вызывает цитопатический эффект; в однослойных культурах под агаровым покрытием образует бляшки. К вирусу восприимчивы белые мыши, морские свинки, кролики, хомяки, белые и хлопковые крысы, а также другие лабораторные животные. Штаммы вируса восточного энцефаломиелита лошадиного разделяют на две антигенные группы, одна из которых объединяет северо-американские штаммы, другая — штаммы, выявленные в Центральной и Южной Америке. В северо-восточных районах США часто регистрируются крупные эпизоотии среди фазанов, вызванные вирусом восточного энцефаломиелита лошадиного.
Источники возбудителей восточного энцефаломиелита лошадиного не установлены, однако неоднократное выделение вируса восточного энцефаломиелита лошадиного от диких птиц многих видов позволяет предположить, что эти птицы являются источниками возбудителя инфекции. Кроме того, существует мнение, что лошади и мулы в период эпизоотий восточного энцефаломиелита лошадиного также могут быть источником возбудителя инфекции. Переносчиками вируса служат комары (см. Комары кровососущие). Естественная зараженность установлена у комаров 12 видов; чаще других оказываются инфицированными комары Culex nig-ripalpus, С. taeniopis, С. restuans,С. salinarius, Culiseta melanura, Aedes vexans, Anopheles crucians u Mansonia perturbans.
Вирус восточного энцефаломиелита лошадиного попадает в кровь человека от зараженных комаров во время кровососания. Через эндотелий капилляров он проникает в ткань мозга, где происходит его размножение и проявляется прямое повреждающее действие на нервные клетки.
Основными патоморфологическими признаками восточного энцефаломиелита лошадиного являются отек и полнокровие головного и спинного мозга, внутренних органов. При микроскопическом исследовании головного мозга выявляют диффузный менингоэнцефалит с обширным вовлечением в процесс нейронов (от небольших изменений в ядре и цитоплазме до полного разрушения), а также периваскулярные скопления лейкоцитов.
В процессе инфекции при восточном энцефаломиелите лошадином вырабатывается напряженный и длительный иммунитет; в организме больного вырабатываются антигемагглютинины, комплементсвязывающие и вируснейтрализующие антитела (см.). Повторных заболеваний не наблюдается.
Инкубационный период длится 5—15 дней. Заболевание начинается с резкого подъема температуры (до 39—41°), рвоты. В течение 24—48 часов развивается сонливость или коматозное состояние, появляются судороги. При обследовании больного обнаруживают ригидность затылочных мышц и спастическое состояние других мышц, отсутствие брюшных рефлексов, отек лица и нижних конечностей, цианоз.
Диагноз устанавливают на основании клинической картины, данных эпидемиологического анамнеза (пребывание в местности возможного распространения восточного энцефаломиелита лошадиного) и результатов лабораторных исследований. В крови выявляется полиморфно-ядерный лейкоцитоз, в цереброспинальной жидкости — лимфоцитарный плеоцитоз (до 1000 клеток в 1 мкл). Для выделения вируса берут кровь лихорадящих больных. Исследуемый материал вводят в мозг и в брюшную полость белых мышей-сосунков, в амниотическую полость куриных эмбрионов или в культуру восприимчивых клеток (обычно фибробласты куриного эмбриона). У мышей вирус восточного энцефаломиелита лошадиного вызывает тремор, атаксию и смерть; куриные эмбрионы погибают; в культуре восприимчивых клеток развивается цитопатический эффект. Для выявления специфических антител в сыворотке крови больных и переболевших используют следующие реакции: реакцию подавления гемагглютинации (см. Гемагглютинация) — антигемагглютинины появляются к концу 1-й недели болезни; реакцию связывания комплемента (см.) — комплемент-связывающие антитела обнаруживаются к концу 2-й недели болезни; реакцию нейтрализации (см. Вирусологические исследования) — нейтрализующие антитела выявляются на 3—4-й неделе болезни.
Дифференцировать восточный энцефаломиелит лошадиный следует с западным и венесуэльским энцефаломиелитами лошадиными (см. ниже), серозными менингитами (см. Менингит) и энцефалитами различной этиологии (см. Энцефалиты), бешенством (см.). Окончательный диагноз может быть установлен только после получения результатов вирусологического и серологического исследований.
Лечение включает дезинтоксикацию (введение растворов глюкозы, солей и т. п.), дегидратацию (назначают лазикс, маннитол и т. п.) а симптоматические средства.
Летальность при восточном энцефаломиелите лошадином достигает 75%. У детей младше 5 лет после перенесенного заболевания часто наблюдается задержка умственного развития, параличи.
Для специфической профилактики восточного энцефаломиелита лошадиного используют инактивированную культуральную вакцину (см. Вакцины), которую применяют для профилактики возможности заболевания при проведении лабораторных исследований и при угрозе заражения восточным энцефаломиелитом лошадиным в природных очагах. Используют также средства защиты от нападения комаров — репелленты (см.), защитные сетки (см.).
Западный лошадиный энцефаломиелит
Помимо США, заболевания людей выявлены в Канаде, Бразилии, Перу, Чили, Аргентине.
Возбудитель западного энцефаломиелита лошадиного и— вирус, принадлежащий к роду Alphavirus семейства Togaviridae. Он обладает многими общими свойствами с вирусом восточного энцефаломиелита лошадиного. Среди штаммов вируса западного энцефаломиелита лошадиного наблюдаются некоторые антигенные различия, позволяющие выделить 2 антигенных варианта — восточный и западный.
Предполагается, что источниками возбудителя инфекции в природных очагах западного энцефаломиелита лошадиного являются дикие птицы, на что указывает выделение вируса из крови птиц многих видов. В антропоургических очагах источниками инфекции являются лошади и мулы. В западных штатах США основная роль в передаче вируса лошадям и человеку принадлежит комарам Culex tarsalis, в других районах переносчиком является Culise-ta melanura. Инфицированными оказались также комары Culex peus,С. pipiens, С. quinquefasciatus, Aedes melanimon, A. nigromaculus и Anopheles freeborni, что может указывать на их возможную роль в переносе вируса.
Заболевания людей в США наблюдаются преимущественно в летние месяцы. Среди заболевших преобладают жители сельской местности; до четверти случаев составляют заболевания детей младше 1 года. До применения специфических вакцин регистрировалось значительное число заболеваний западным энцефаломиелитом лошадиным среди сотрудников вирусологических лабораторий. Заражение людей вирусом западного энцефаломиелита лошадиного часто ведет к бессимптомной инфекции, в результате которой в организме вырабатываются специфические антитела. Ривс (W. С. Reeves) и сотрудники (1962) считают, что в очагах западного энцефаломиелита лошадиного один случай заболевания энцефаломиелитом среди детей в возрасте до 5 лет приходится примерно на 58 случаев инфицирования; с возрастом это отношение изменяется и составляет среди лиц старше 15 лет 1:1150.
Микроскопические изменения в головном мозге (сером веществе, базальных ядрах, среднем мозге и мозжечке) заключаются в очаговом некрозе с деструкцией нейронов и скоплении одноядерных, преимущественно микроглиальных клеток. При быстром летальном исходе обнаруживаются микроскопические геморрагические очаги в варолиевом мосту (мост головного мозга, Т.) и в продолговатом мозге.
Патогенез и характер развития иммунитета западного энцефаломиелита лошадиного сходны с восточным.
Инкубационный период при западном энцефаломиелите лошадином варьирует от 4 до 21 дня, чаще 5—10 дней. Болезнь обычно начинается с быстрого кратковременного подъема температуры до 39—40°. Судороги наблюдаются более чем у 90% детей в возрасте до 1 года, у 40% детей — в возрасте 1—4 лет и редко у взрослых больных. К частым симптомам у детей относятся головная боль, рвота, ригидность мышц затылка и спины. У взрослых возможны также сонливость, заторможенность, развитие коматозного состояния. Острый период продолжается 7—10 дней. Более чем у половины детей в возрасте до 1 года после перенесенного заболевания сохраняются остаточные явления — судороги, конвульсии, нарушения двигательной функции и психической деятельности. У более старших детей и взрослых остаточные явления менее выражены и кратковременны или полностью отсутствуют.
Диагноз устанавливают на основании клинической картины, данных эпидемиологического анамнеза (пребывание в местности возможного распространения западного энцефаломиелита лошадиного) и лабораторных исследований. Выделение вируса и обнаружение антител проводят так же, как при восточном энцефаломиелите лошадином; картина крови и состав цереброспинальной жидкости сходны с таковой при восточном энцефаломиелите лошадином (см. выше). Дифференциальная диагностика аналогична описанной при восточном энцефаломиелите лошадином. Лечение проводится так же, как при восточном энцефаломиелите лошадином.
Летальность при западном энцефаломиелите лошадином достигает 8—15%, среди детей — до 30%.
Специфическая профилактика западного энцефаломиелита лошадиного проводится с помощью инактивированной формалином вакцины, которой преимущественно вакцинируют работников вирусологических лабораторий. Уничтожение комаров в очагах западного энцефаломиелита лошадиного способствует снижению заболеваемости. Используют средства защиты от нападения комаров — репелленты, защитные сетки.
Венесуэльский лошадиный энцефаломиелит
Вирус венесуэльского энцефаломиелита лошадиного принадлежит к роду Alpha virus семейства Toga vir idae. Штаммы вируса вместе с антигенно родственными вирусами Мукабо и Пиксуна образуют 4 антигенные группы.
Факторы, обусловливающие существование природных очагов венесуэльского энцефаломиелита лошадиного, изучены недостаточно. В циркуляции вируса в природе, по-видимому, принимает участие большое число диких животных, однако наибольшее значение, вероятно, имеют грызуны и обезьяны. Вирус неоднократно выделяли от домашних животных — лошадей, мулов, ослов. Переносчиками вируса являются комары. Вирус венесуэльского энцефаломиелита лошадиного в природных очагах был выделен от многих видов комаров, принадлежащих к родам Culex, Aedes, Mansonia, Psorophora, Hae-magogus, Sabethes и Anopheles. Заболевания возникают преимущественно у жителей сельской местности, причем среди заболевших преобладают дети и лица молодого возраста. В отличие от восточного и западного энцефаломиелитов лошадиных установлено выделение вируса венесуэльского энцефаломиелита лошадиного с носоглоточным отделяемым, что предполагает возможность передачи инфекции от человека человеку, хотя документированных случаев такой передачи не описано.
Патогенез венесуэльского энцефаломиелита лошадиного у человека изучен недостаточно.
При патологоанатомическом исследовании выявляют признаки энцефалита — отек и очаговые поражения головного мозга.
Иммунитет после перенесенной болезни стойкий и длительный, вероятно, пожизненный; в процессе болезни вырабатываются антигемагглютинины, комплементсвязывающие и вируснейтрализующие антитела.
Инкубационный период составляет 2—6 дней, может быть укорочен до 1 суток. Заболевание начинается остро, с сильной головной боли, озноба, кратковременного подъема температуры, мышечных болей, тошноты и рвоты. Эти явления сопровождаются гиперемией конъюнктивы и слизистых оболочек зева и глотки. У небольшой части больных наблюдаются признаки энцефалита: судороги, нарушения сознания от сонливости до развития коматозного состояния. В случае легкого течения заболевания эти симптомы исчезают через 3—5 дней, в более тяжелых случаях — через 8—10 дней.
Диагноз устанавливают на основании клинической картины и данных эпидемиологического анамнеза. Подтверждают диагноз выделением вируса и обнаружением специфических антител по такой же методике, как при восточном энцефаломиелите лошадином. Картина крови и цереброспинальной жидкости сходна с таковой при восточном энцефаломиелите лошадином. (см. выше).
Лечение проводится так же, как при восточном энцефаломиелите лошадином. Выздоровление обычно полное. У части больных после перенесенного энцефалита наблюдаются упорные головные боли, астения, приступы судорог.
Профилактические меры включают истребление комаров, защиту от нападения их в очагах венесуэльского энцефаломиелита лошадиного и прививку вакциной. Установлено, что истребление комаров сдерживает распространение эпидемий. Для вакцинации людей, подвергающихся риску заражения, используют вакцину из аттенуированного штамма ТС-83, а также инактивированную вакцину.
Библиогр.: Общая и частная вирусология, под ред. В. М. Жданова и С. Я. Гайдамович, т. 2, с. 49, М., 1982; Руководство по зоонозам, под ред. В. И. Покровского, с. 78, Л., 1983; Федоров Ю. В. и Соляник Р. Г. Биологические свойства и изменчивость вирусов лошадиных энцефаломиелитов, Томск, 1977, библиогр.; Control of communicable diseases in man, ed. by A. S. Benenson, Washington,1981.
Читайте также:
